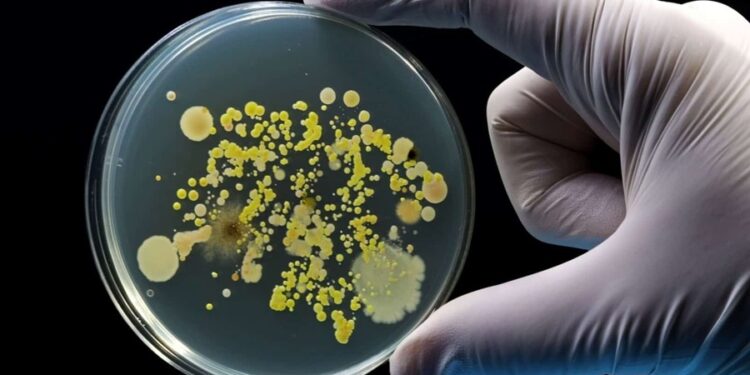
Cimento feito usando bactérias vira nova tendência da construção

Pesquisadores da Universidade de Aarhus, na Dinamarca, e da Universidade Chongqing Jiaotong, na China, anunciaram o desenvolvimento de um novo material conhecido como “cimento vivo”.
A inovação consiste em incorporar bactérias eletroativas da espécie Shewanella oneidensis à mistura tradicional de cimento. O resultado é um compósito capaz de armazenar energia elétrica, abrindo caminho para a integração entre infraestrutura urbana e geração de energia renovável.
As bactérias, em vez de perderem suas funções ao serem incorporadas, interagem com a matriz sólida e mantêm suas propriedades eletroativas. Esse processo cria uma rede condutora dentro do material, permitindo o armazenamento dinâmico de energia. Em termos práticos, o próprio cimento passa a atuar como parte de um circuito eletroquímico.

Como funciona a produção do cimento vivo
A preparação do cimento vivo começa com o cultivo das bactérias em meio de cultura, que preserva sua capacidade de transferência de elétrons. Em seguida, elas são diluídas em água deionizada para compor a parte líquida da mistura. Ao cimento Portland tradicional é adicionado sulfato de sódio, que atua como eletrólito, formando a base seca do material.
Quando as duas partes são unidas, a suspensão bacteriana se espalha pela matriz do cimento. O material é então moldado, vibrado para retirada de bolhas e curado em temperatura ambiente. O cimento resultante não só mantém as características estruturais necessárias para a construção civil, como também se transforma em um reservatório de energia renovável.
Nos testes laboratoriais, o cimento vivo demonstrou capacidade de armazenar 178,7 Wh/kg, energia suficiente para manter dezenas de lâmpadas LED acesas por uma hora. Após 10 mil ciclos de carga e descarga, o material ainda retinha 85% da capacidade inicial, mesmo em variações de temperatura entre –15°C e 33°C.